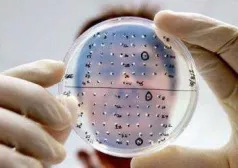

От «Нашей Газеты» — к «Русскому акценту»
Новый культурный блог
Русский · English · Français
Культура говорит на всех языках, с разными акцентами
![]()

От «Нашей Газеты» — к «Русскому акценту»
Новый культурный блог
Русский · English · Français
Культура говорит на всех языках, с разными акцентами
![]()

От «Нашей Газеты» — к «Русскому акценту»
Новый культурный блог
Русский · English · Français
Культура говорит на всех языках, с разными акцентами
![]()